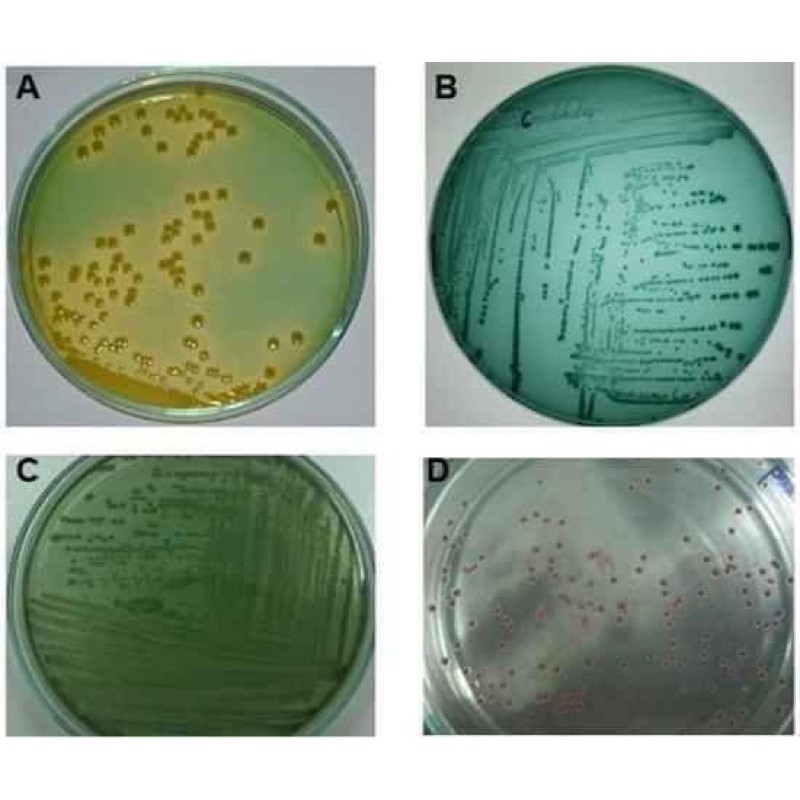

ĐIỂM XÉT NGHIỆM TÔM MIỄN PHÍ TẠI ĐBSCL
CÙNG CHIA SẺ RỦI RO - GIẢM CHI PHÍ SẢN XUẤT VÀ NÂNG CAO CHẤT LƯỢNG PHỤC VỤ KHÁCH HÀNG LÀ MỤC TIÊU CỦA "ĐIỂM XÉT NGHIỆM TÔM MIỄN PHÍ" ĐANG ĐƯỢC THỰC HIỆN THÍ ĐIỂM CỦA CÔNG TY TNHH ĐẦU TƯ THỦY SẢN MEKONG AQUA TẠI ĐBSCL
Tại đây bà con NUÔI TRỒNG THỦY HẢI SẢN được hỗ trợ kiểm tra MIỄN PHÍ các chỉ tiêu môi trường ao nuôi như: tảo, pH, kiềm, NH3…. Không chỉ giảm chi phí đầu vào cho bà con nông dân, Điểm xét nghiệm tôm miễn phí còn hướng người nuôi tôm có thói quen kiểm tra chất lượng nước trước và trong quá trình nuôi nhằm đảm bảo tỉ lệ thành công vụ nuôi cao
Hình 1.1 & 1.2 : Một điểm xét nghiệm tôm miễn phí của Công ty TNHH Đầu tư Thủy sản Mekong Aqua tại ĐBSCL
Hình 2.1 & 2.2: Bộ tiểu phẫu tôm
Hình 3: Kính hiển vi kiểm tra tảo trong ao nuôi. Khuẩn và KST trong gan và đường ruột tôm
Hình 4: Đĩa TCBS kiểm tra mật độ khuẩn môi trường ao nuôi trồng thủy sản
Hình 5.1
,
Hình 5.2
,
Hình 5.3
Hình 5.4
Hình 5.5
Hình 5.6
Hình 5.7
,
Hình 5.8
Hình 5.9
Hình 5.1 - 5.9 : Một số bộ text thông dụng

Xem thêm